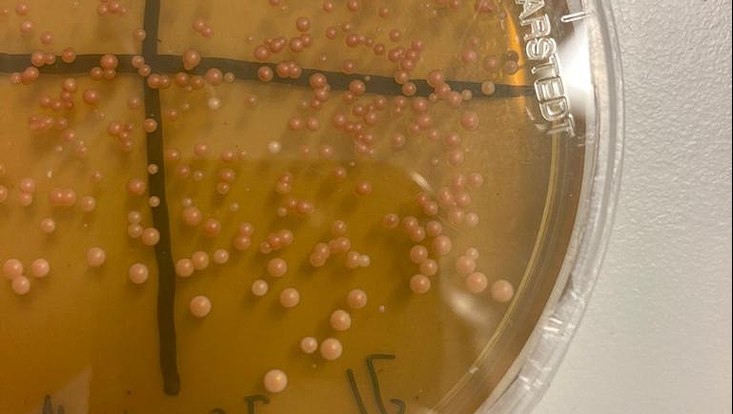
biogenetik-wise-22-23-10-733x414 Das Foto zeigt eine gelbliche Agarplatte mit Bakterienkolonien.
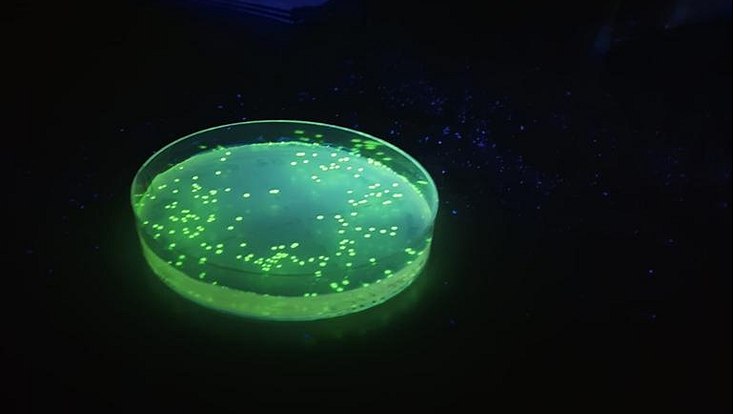
biogenetik-wise-22-23-8-733x414 Das Foto zeigt eine Agarplatte, die unter UV-Licht leuchtet.

Studium
Die Studiengänge Molecular Life Sciences (Bachelor of Science (B.Sc.) und Master of Science (M.Sc.)) sind interdisziplinär ausgerichtet und vereinen die Grundlagen aus den Bereichen der Biologie, Medizin, Chemie und Physik.
Wie der Name schon sagt, befasst sich der Studiengang mit der Wissenschaft über das Leben auf molekularer Ebene. Dies beinhaltet die Lehre über Zellen, Stoffwechsel, virale und bakterielle Krankheiten, Signaltransduktion und Onkologie.
Da das Studium zu über 50% aus praktischem Arbeiten besteht, lernst du zahlreiche Techniken der Biochemie und Molekularbiologie kennen, z.B. Klonierung von DNA, Proteinanalyse, Aufklärung molekularer Strukturen.
Außerdem werden Grundlagen in Themenbereichen der anorganischen und organischen Chemie, Tier- und Pflanzenphysologie, Strukturbiochemie und Bioinformatik gelehrt, die nach Interesse in Form von Wahlmodulen vertieft werden können.
Im 5. Semester des Bachelorstudiengangs findet ein sechswöchiges Betriebspraktikum statt, welches Einblicke in das Arbeiten im biochemischen Berufsleben bietet.